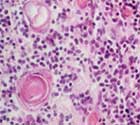

Pesquisadores identificam mutação genética responsável pela imunodeficiência combinada grave, doença caracterizada por problemas como infecções graves na pele, asma e até câncer
Pesquisadores identificam mutação genética responsável pela imunodeficiência combinada grave, doença caracterizada por problemas como infecções graves na pele, asma e até câncer
Pesquisadores identificam mutação genética responsável pela imunodeficiência combinada grave, doença caracterizada por problemas como infecções graves na pele, asma e até câncer
Pesquisadores identificam mutação genética responsável pela imunodeficiência combinada grave, doença caracterizada por problemas como infecções graves na pele, asma e até câncer
A desordem, chamada de imunodeficiência combinada grave, é caracterizada por uma série de problemas de saúde severos, entre os quais infecções bacterianas e virais persistentes de pele, eczema grave, alergias agudas, asma e câncer.
A imunodeficiência combinada grave é um tipo de deficiência imunológica primária no qual várias partes do sistema imunológico são afetadas. Trata-se de uma desordem herdada caracterizada pelo aumento na suscetibilidade a infecções bacterianas, virais e fúngicas em vários órgãos do corpo. Em alguns casos, a suscetibilidade a cânceres também pode ocorrer.
Há 150 tipos conhecidos de deficiência imunológica primária, com cerca de 500 mil pessoas nos Estados Unidos diagnosticadas com a condição. A equipe que fez a descoberta foi conduzida por Helen Su, do Instituto Nacional de Alergia e Doenças Infeccionas (Niaid), e os resultados foram publicados no New England Journal of Medicine.
Os cientistas sabiam que certos pacientes com uma forma indefinida da imunodeficiência combinada compartilham características clínicas suficientes para que a causa pudesse ser uma mutação genética comum.
Originalmente, pensou-se que esses indivíduos tivessem uma forma da síndrome de Jó ou de hiperimunoglobulinemia E, desordem caracterizada por níveis aumentados de uma classe de anticorpos conhecidos como imunoglobulina E, por infecções bacterianas e fúngicas superficiais e sistêmicas, além de eczema.
O grupo de voluntários do estudo, contudo, tinha eczemas muito mais severos do que normalmente se vê em casos da síndrome de hiperimunoglobulinemia E. Os pacientes também tinham infecções virais na pele extensas e de difícil tratamento. Alguns desenvolveram câncer de pele.
“Apesar de terem sido diagnosticados com uma forma rara de síndrome de hiperimunoglobulinemia E, ainda assim consideramos que eles tinham uma doença desconhecida, por conta das alergias severas e do desenvolvimento de tumores”, disse Helen.
Com o uso da técnica de hibridização genômica, processo por meio do qual grandes quantidades de DNA são fixadas em um chip e analisadas em computador em busca de alterações genéticas, os pesquisadores examinaram os genes nas amostras de tecido de pessoas de cinco grupos diferentes: com imunodeficiências desconhecidas; com a variante da síndrome de hiperimunoglobulinemia E; com a forma clássica da síndrome; com outras doenças imunológicas; e indivíduos sadios.
Os cientistas descobriram que as pessoas com a variante da síndrome apresentaram mutações em um gene chamado de Dock8. Essas mutações causaram eliminações em partes do próprio gene. Quando comparados com pessoas saudáveis, os pacientes com mutações no Dock8 apresentaram menos linfócitos T CD8 positivos, células imunes necessárias para o combate a infecções causadas por vírus.
Os pacientes também tinham menos células B produtoras de anticorpos e um aumento no número de eosinófilos, células imunes associadas com casos de alergia.
De acordo com os autores do estudo, os resultados indicam que o Dock8 é essencial para a defesa contra infecções virais e para a prevenção do desenvolvimento de cânceres e alergias.
Embora mais estudos sejam necessários para determinar se as mutações no Dock 8 ocorrem em outras pessoas com sintomas semelhantes, a variante da síndrome de hiperimunoglobulinemia E causada por mutações no gene pode ser um novo tipo de deficiência imunológica primária, apontam.
O artigo Combined immunodeficiency associated with Dock8 mutations, de Helen Su e outros, pode ser lido por assinantes do New England Journal of Medicine em Erro! A referência de hiperlink não é válida.>.
Republicar
A Agência FAPESP licencia notícias via Creative Commons (CC-BY-NC-ND) para que possam ser republicadas gratuitamente e de forma simples por outros veículos digitais ou impressos. A Agência FAPESP deve ser creditada como a fonte do conteúdo que está sendo republicado e o nome do repórter (quando houver) deve ser atribuído. O uso do botão HMTL abaixo permite o atendimento a essas normas, detalhadas na Política de Republicação Digital FAPESP.





